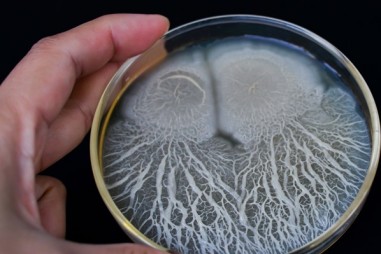
Các nhà nghiên cứu sử dụng bào tử vi khuẩn mã hóa DNA để cải thiện khả năng truy xuất nguồn gốc thực phẩm

Mùi của xe ô tô mới mua có thể gây ung thư?
TNNN - Nếu liên tục lái một chiếc xe ô tô mới trong hơn 20 phút mỗi ngày, lượng benzen và formaldehyde mà bạn hít phải sẽ vượt quá ngưỡng quy định.

TNNN - Nếu liên tục lái một chiếc xe ô tô mới trong hơn 20 phút mỗi ngày, lượng benzen và formaldehyde mà bạn hít phải sẽ vượt quá ngưỡng quy định.

TNNN - Chế phẩm canthaxanthin có nguồn gốc tự nhiên do Viện Hóa học các hợp chất thiên nhiên tổng hợp đạt tỷ lệ >70%, đảm bảo ATTP và giúp giảm chi...

TNNN - Mặc dù có thể gây ra các vấn đề nghiêm trọng về sức khỏe con người, nhưng các nguồn gây bệnh do ký sinh trùng gây ra vẫn chưa được kiểm soát.

TNNN - Mỗi năm, Bệnh viện thực hiện hơn 40 nghìn ca đẻ, hơn 25 nghìn ca phẫu thuật sản phụ khoa, hàng chục ngàn ca thủ thuật và gần một triệu lượt...

TNNN - Việt Nam đã sản xuất thành công hóa chất khử khuẩn Cloramin B đủ tiêu chuẩn sử dụng trong gia dụng và y tế.

TNNN - Các nhà vật lý hạt nhân đã tiến đến gần thời điểm có thể chế ngự một nguồn năng lượng sạch hầu như vô tận - năng lượng tổng hợp hạt nhân trong...

TNNN - Một cơ hội lớn cho việc phát triển y học chính xác ở Việt Nam đã được mở ra với sự hợp tác của các trường đại học ở nhiều lĩnh vực nghiên cứu...

TNNN - Truy xuất nguồn gốc là giải pháp để người tiêu dùng trực tiếp kiểm tra các thông tin của sản phẩm cuối cùng: nơi sản xuất, vật tư sử dụng, sơ...

TNNN – Đề tài mở ra hướng nghiên cứu mới trong việc thu hồi các kim loại quý hiếm có giá trị kinh tế cao từ quặng và bã thải ở Việt Nam.

TNNN - Sợi quang làm từ agar có thể ăn được, tương thích sinh học và phân hủy sinh học, mở ra nhiều ứng dụng mới cho ngành y tế.

TNNN - Phương pháp được phát triển bởi các nhà nghiên cứu của Đại học Cordoba, có thể được sử dụng trong các phòng thí nghiệm kiểm soát chất lượng...

TNNN - Xác định những nguồn protein mới cho chăn nuôi từ côn trùng và tảo có làm thay đổi chất lượng thịt truyền thống hay không.

TNNN - Công nghệ "phơi nước" mới này được hy vọng sẽ giải quyết các vấn đề về hạn hán, ô nhiễm nguồn nước của nhiều khu vực trên thế giới.

TNNN - Covid-19 có thể gây ra các cục máu đông nguy hiểm chết người. Các nhà nghiên cứu tin rằng họ đã tìm ra cách chúng hình thành, từ đó có thể...

TNNN - Hơi nước trong khí quyển cũng có thể trở thành một nguồn cấp điện tái tạo cực kỳ tiềm năng trong tương lai gần.
TNNN - Nhóm nghiên cứu đã mô tả bằng cách nào các bào tử vi khuẩn tổng hợp có thể được đưa vào các vật thể và bề mặt một cách an toàn tại một điểm...

TNNN – Công nghệ blockchain sẽ là nền tảng vững chắc để hơn 11.000 hợp tác xã nông nghiệp Việt Nam đưa sản phẩm vươn tầm quốc tế.

TNNN - Truy xuất nguồn gốc hàng hóa theo tiêu chuẩn quốc tế là xu hướng ngày càng được khách hàng trong và ngoài nước yêu cầu.

TNNN - Tổ chức Nghiên cứu Hạt nhân châu Âu (CERN) thực hiện thử nghiệm gần nhất nhằm xác định xem hạt Higgs có thể phân rã thành vật chất tối hay...

TNNN - Các FTA tạo cơ hội mở rộng thị trường nhưng cũng khiến hàng hóa Việt Nam đối mặt với nhiều rào cản về tiêu chuẩn, chất lượng, truy xuất nguồn...

TNNN - Màng mỏng 2D perovskite tăng độ nhạy gấp 100 lần so với các máy dò thông thường mà không yêu cầu nguồn điện bên ngoài.

TNNN – Có đến 26 giống lợn bản địa, Việt Nam được đánh giá là một trong những nước có nguồn gen lợn bản địa đa dạng và phong phú.